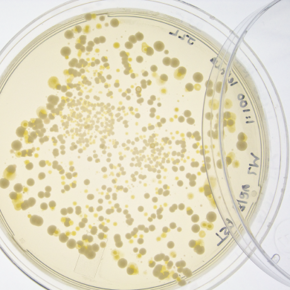
Picture for category LABORATORY

0
You have no items in your shopping cart.
Close
Menu
Products tagged with 'superstart blanc'
Superstart™ Blanc and Rosé (Various Sizes)
SUPERST-BLANC-1-VAR
Yeast rehydration formulation optimized specifically for yeasts used in white and rosé wines winemaking. Patent FR 2736651.
From $49.76
Categories
Information
Customer service
Copyright © 2025 Laffort. All rights reserved.
Filters
Sort
display